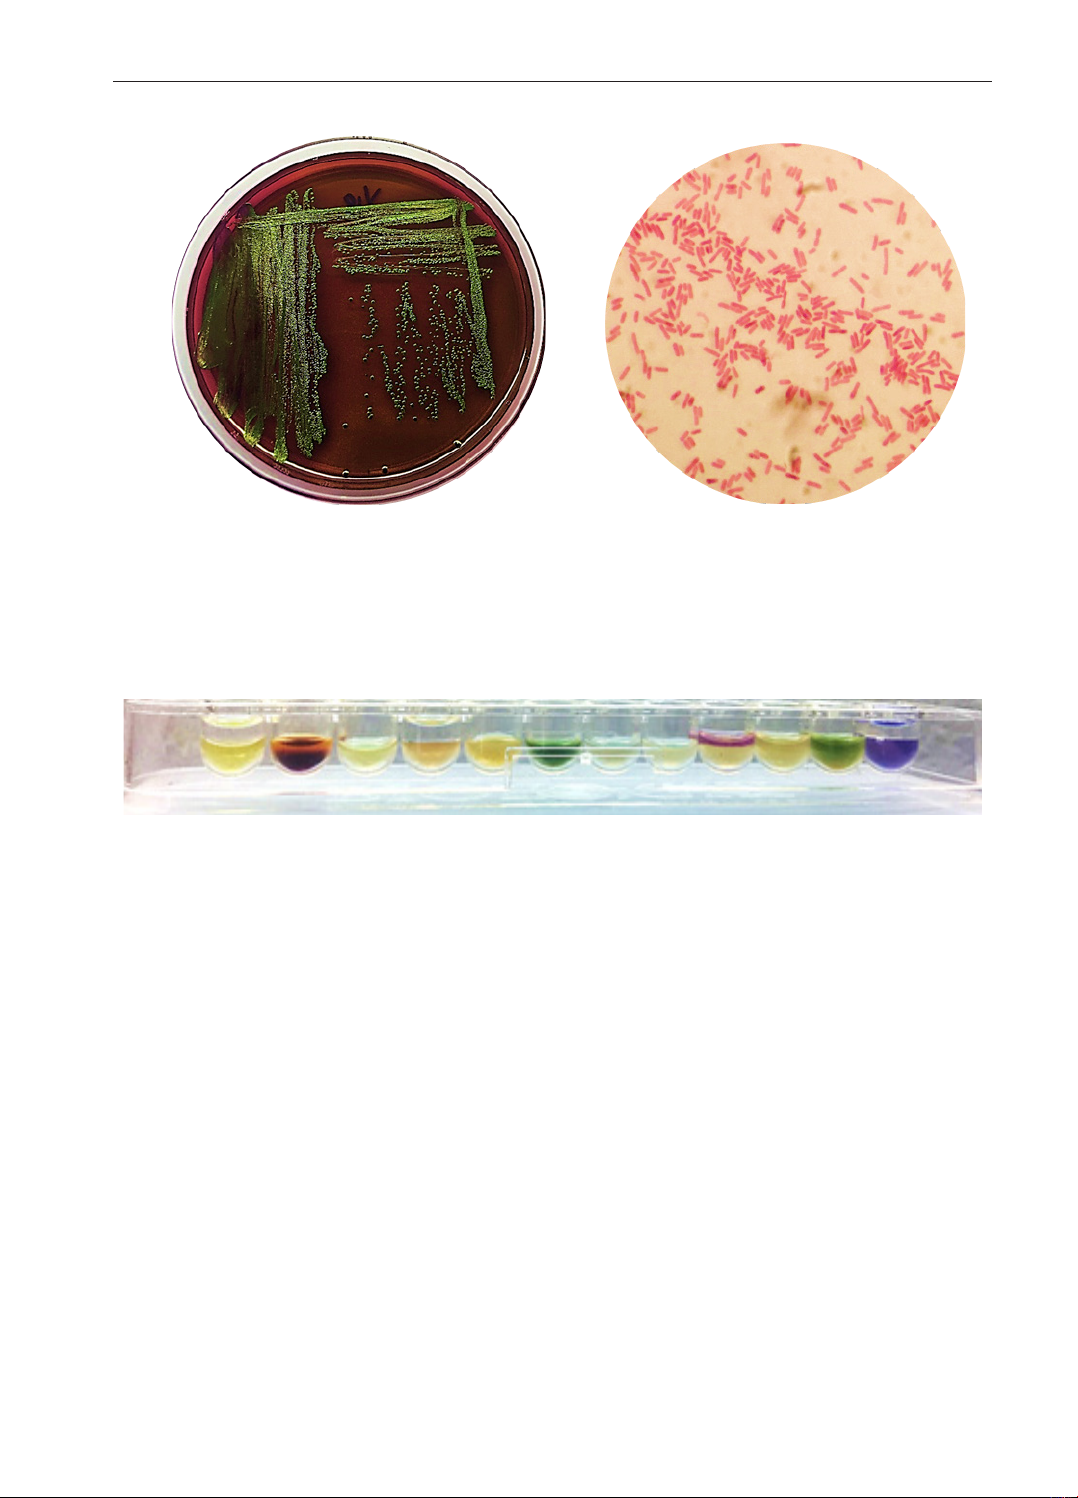

18
KHOA HỌC KỸ THUẬT THÚ Y TẬP XXXI SỐ 8 - 2024
NGHIEÂN CÖÙU VEÀ MÖÙC ÑOÄ NHAÏY CAÛM KHAÙNG SINH CUÛA CAÙC GOÁC
VI KHUAÅN
ESCHERICHIA COLI
PHAÂN LAÄP TÖØ PHAÂN CHOÙ TAÏI
CAÙC PHOØNG KHAÙM THUÙ Y THUOÄC TP. HOÀ CHÍ MINH
Lê Hoàng Trúc Vân, Nguyễn Thị Ngọc Ngân, Cao Chí Nguyên,
Lê Hữu Ngọc, Lâm Ánh Tuyết, Đặng Thị Xuân Thiệp*
Khoa Chăn nuôi Thú y, Đại học Nông Lâm Tp. HCM
*Tác giả liên hệ email: thiep.dangthixuan@hcmuaf.edu.vn
TÓM TẮT
Nghiên cứu được thực hiện nhằm đánh giá mức độ nhạy cảm kháng sinh của các vi khuẩn
Escherichia coli(E. coli)phânlậptừmẫuphânchóđượcthuthậpngẫunhiên,tạicácphòngkhám
thúytrênđịabànThànhphốHồChíMinh.Phươngphápkhuếchtántrênthạch(diskdiffusion)được
sửdụngđểđánhgiámứcđộnhạycảmcủa40gốcvikhuẩnE. colivới12khángsinhthửnghiệm
theohướngdẫncủaCLSI(2021).Kếtquảnghiêncứuchothấy,trongtổngsố47mẫuphânđãphân
lậpvàđịnhdanhđược40gốcvikhuẩnE. coli;chiếmtỷlệ85,1%.CácvikhuẩnE. coliphânlập
đượcnhạycảmcaonhấtvớicáckhángsinhimipenem,meropenem,amikacinvớitỷlệhơn70%,tiếp
đếnlàcefepime,gentamicin,trimethoprim/sulfamethoxazolevớitỷlệdưới50%.Cácgốcvikhuẩn
phânlậpđượcítnhạycảmvớitetracycline(5%),amoxicillin-clavulanatevàdoxycycline(2,5%),và
khôngnhạycảmvớichloramphenicol.Hầuhếtcácgốcvikhuẩnchokiểuhìnhđađềkháng(97,5%).
Từ khóa: E. coli,nhạycảmkhángsinh,chó,phânlập,địnhdanh,TP.HồChíMinh.
Study on antimicrobial susceptibility of Escherichia coli isolated
from dog feces at veterinary clinics in Ho Chi Minh City
Le Hoang Truc Van, Nguyen Thi Ngoc Ngan, Cao Chi Nguyen,
Le Huu Ngoc, Lam Anh Tuyet, Dang Thi Xuan Thiep
SUMMARY
This study was conducted to determine the antimicrobial susceptibility of Escherichia coli
(E. coli) isolated from the fecal samples of dogs at veterinary clinics in Ho Chi Minh City. The
disk diffusion method was used to evaluate the susceptibility of 40 E. coli strains to 12 tested
antibiotics according to CLSI guidelines (2021). The studied results showed that from the total
of 47 stool samples, 40 E. coli strains were isolated and identified, accounting for 85.1%. E.
coli isolates were most susceptible with imipenem, meropenem, and amikacin (>70%); with
cefepime, gentamicin, and trimethoprim/sulfamethoxazole, the susceptibility was under 50%.
The isolates were susceptible with tetracycline was low (5%), amoxicillin-clavulanate and
doxycycline (2.5%) but was not susceptible with chloramphenicol. Most of the isolates were
multi-resistant phenotypes (97.5%).
Keywords: E. coli, antibiotic susceptibility, dog, isolation, identification, Ho Chi Mịnh City.
I. ĐẶT VẤN ĐỀ
HộinghịquốctếPetFairSouthEastAsia
năm2022khẳngđịnhxuhướngnuôithúcưng
ởViệtNamhiệnnayđangpháttriểnmạnhmẽ,
với tỷ lệ hộ gia đình sở hữu thú cưng có sự
tăngtrưởngquacácnăm(PetFairSouth-East
Asia,2022).Tp.HCMlàtrungtâmkinhtếcủa

19
KHOA HỌC KỸ THUẬT THÚ Y TẬP XXXI SỐ 8 - 2024
cảnướcvớisựpháttriểnvềlĩnhvựcthúnhỏ
ngày một lớn mạnh, mạng lưới phòng khám
thúyđanghoạtđộngtạiđịabàncũngdầnmở
rộng. Theo đó, các tương tác giữa thú nuôi
vớicácnhânviênngànhthúycũngvìvậymà
nhiềuhơn.Sốlượngthúcưng,đặcbiệtlàchó
cóxuhướngtăngdonhucầunuôithúcảnhcủa
ngườidân,tỷlệthuậnvớisựtươngtácgiữa
chủvàthúnuôi(VnExpress,2021).Mậtđộthú
cưngđông,nhucầunuôicaodẫnđếnáplực
lớnvềmầmbệnh,đikèmkhảnăngtruyềnlây
vậtchấtđađềkhángthuốc,màcụthểlàkháng
sinh,giữađộngvậtvớiđộngvật,vàgiữađộng
vậtvớiconngười.
Escherichia coli (E. coli) làvikhuẩngram
âm, có hình dạng trực khuẩn, thường trú tại
đường ruột của các loài động vật, đặc biệt ở
trongphân(Gyles,2010).Vikhuẩncókhảnăng
gâyracácbệnhcơhội,đồngthờiđượcbiếtđến
rộngrãivớikhảnăngmangvàtruyềnlâycác
yếutốđađềkhángvớicácnhómkhángsinhphổ
rộng(Schaufleret al.,2015).Ghinhận62,42%
vikhuẩnE. colitrênchónhàđađềkhángvới
các kháng sinh, xấp xỉ 40% E. coli sản sinh
β-lactamasekhángkhángsinhphổrộng(Zhou
et al.,2022).CósựhiệndiệnvikhuẩnE. coli
manggenđềkhángcarbapenemtừchócủacác
hộgiađìnhtạiTrungQuốc(Liet al.,2019).Vi
khuẩnE. colisảnsinhcarbapenemaseđãđược
phânlậptừmẫuphếttrựctràngcủachótạicác
bệnhviệnthúyởHànQuốc,cũngnhưtìmra
vậtchấttruyềnlâyvàconđườngtruyềnlâytừ
ngườisangthú(Honget al.,2020).Cóthểthấy,
việctiếpxúcgiữanhânviênthúyvớithúcưng
cóthểlâynhiễmnhữngvikhuẩnnày.
Vi khuẩntồntạikhảnănglanrộngcác yếu
tốnguyhiểmtrênracộngđồng,đòihỏichúng
tathậtsựnghiêmtúcýthứcđượcvấnđề.Tuy
nhiên,cácnghiêncứuvềchủđềnàytrongnước
hiệnchưađượcphongphúvàrộngrãi.Dođó,
nghiêncứucủachúngtôiđượcthựchiệnnhằm
đánhgiámứcđộmẫncảmkhángsinhcủacácE.
coli phânlậpđượcbằngphươngphápkhuếchtán
trênthạch.Kếtquảnghiêncứusẽgópphầnđánh
giámứcđộnhạycảmcủaE. coli,cungcấpcơ
sởdữliệutrongđiềutrịbệnhdoE. colitrênchó,
đồngthờinângcaoýthứctrongsửdụngkháng
sinh,bảovệsứckhỏecộngđồng.
II. NỘI DUNG, VẬT LIỆU VÀ
PHƯƠNG PHÁP NGHIÊN CỨU
2.1. Nội dung nghiên cứu
-PhânlậpvàđịnhdanhcácgốcvikhuẩnE.
colitừcácmẫuphânchóthuthậptạicácphòng
khámthúytrênđịabànTp.HCM.
-Xácđịnhmứcđộnhạycảmkhángsinhcủa
40gốcvikhuẩnE. coliđãphânlậpvớicáckháng
sinhthửnghiệmbằngphươngphápkhuếchtán
trênthạchtheohướngdẫncủaCLSI(2021).
-XácđịnhkiểuhìnhđềkhángcủacácgốcE.
coliphânlậpđược.
2.2. Vật liệu và phương pháp nghiên cứu
2.2.1. Phân lập và định danh vi khuẩn
* Thu thập mẫu
Tổng số 47 mẫu phân chó được thu thập
ngẫu nhiên từ 6 phòng khám thú y thuộc Tp.
HCM.Dùngtămbôngvôtrùngngoáyvàotrực
tràngthúđểthuthậpmẫu,sauđóchotămbông
vàotúiđựngmẫu.Cácmẫusaukhithuthậpcho
vàothùngđựngmẫu,bảoquảnbằngđákhôvà
vậnchuyểnvềphòngthínghiệmtrongvòng24
giờđểtiếnhànhphânlập,địnhdanh.
* Phân lập
Môitrường phânlập được sửdụng là môi
trườngEMB(EosinMethyleneBlue,HiMedia).
Với các mẫu phân, sử dụng mẫu tăm bông
ngoáyphânphếttrựctiếp3-4đườngcấy,cácđĩa
nuôicấyvikhuẩnđượcủhiếukhíở37°Ctrong
vòng24giờ.Sauthờigiannuôicấy,việcnhận
diệnvikhuẩnmụctiêudựavàohìnhtháikhuẩn
lạctròn,trơnbóng,cómàutímánhkimvàkết
quảnhuộmgram(Leiningeret al.,2001).Chọn
cáckhuẩnlạcđiểnhìnhcấytăngsinhvàomôi
trườngNA(NutrientAgar,HiMedia),tiếptụcủ
hiếukhíở37°Ctrongvòng24giờđểchuẩnbị
chobướcđịnhdanhvikhuẩn.
20
KHOA HỌC KỸ THUẬT THÚ Y TẬP XXXI SỐ 8 - 2024
* Định danh vi khuẩn
Vikhuẩnđượcđịnhdanhbằngbộđịnhdanhsinh
hoáIVDNK-IDS14GRNdocôngtyTNHHdịch
vụvàthươngmạiNamKhoa,TP.HCMsảnxuất.
Hình 1. Khuẩn lạc E. coli trên môi trường
EMB (tròn, trơn bóng, tím ánh kim) Hình 2. Hình thái vi khuẩn dưới kính hiển
vi 1000x (gram âm, cầu trực khuẩn)
2.2.2. Xác định mức độ nhạy cảm kháng sinh
của các gốc vi khuẩn E. coli
* Nguyên vật liệu
Tổng số 40 gốc vi khuẩn E. coli đã được
phânlậptừ47mẫuphânchóthuthậptạicác
phòngkhámthúythuộcđịabànTp.HCM.
* Môi trường và các loại kháng sinh
Môi trường MHA (Mueller Hinton Agar;
HiMedia) được sử dụng để thực hiện phương
pháp khuếch tán trên thạch nhằm đánh giá
mứcđộmẫncảmkhángsinhcủacácvikhuẩn
đãphânlập.12khángsinhđượcsửdụngbao
gồm amoxicillin-clavulanate (Ac), cefepime
(Cm), imipenem (Im), meropenem (Me),
gentamicin (Ge), amikacin (Ak), tetracycline
(Te), doxycycline (Dx), ciprofloxacin
(Ci), norfloxacin (Nr), trimethoprim/
sulfamethoxazole(Bt)vàchloramphenicol(Cl)
sảnxuấtbởicôngtyTNHHdịchvụvàthương
mạiNamKhoa,TP.HCM.
* Xác định mức độ nhạy cảm kháng sinh
Phương pháp khuếch tán trên thạch được
thựchiệnđểxácđịnhmứcđộnhạycảmkháng
sinhcủacácgốcvikhuẩntheohướngdẫncủa
CLSI (2021). Vi khuẩn E. coli ATCC 25922
đượcsửdụnglàmđốichứng.
III. KẾT QUẢ VÀ THẢO LUẬN
3.1. Kết quả phân lập vi khuẩn E. coli trong
các mẫu phân
Nghiên cứu đã phân lập được 40 gốc vi
khuẩnE. colitừ47mẫuphânchóthuthậpngẫu
Hình 3. Kt qu định danh sinh hóa của vi khuẩn E. coli

21
KHOA HỌC KỸ THUẬT THÚ Y TẬP XXXI SỐ 8 - 2024
nhiênở6phòngkhámthúytạiTp.HCM.Kết
quả cho thấy vi khuẩn E. coli cho tỷ lệ phân
lập tương đối cao; chiếm 85,1% trên tổng số
mẫuthuthập.Kếtquảnàythấphơnsovớicác
nghiêncứutrướcđóvớitỷlệE. colilầnlượtlà
99%(Schmidtet al.,2015)và98,6%(Amadiet
al.,2019).Trongcácnghiêncứukhác,E. coli
phânlậpđượcvớitỷlệ95%,46%từchónhà
và49%từchóhoang(Marchettiet al.,2021);
628/877mẫuphânchóphânlậpđượcvikhuẩn
E. coli(tỷlệ71,6%)(Namet al.,2010).Tương
tựvớinghiêncứutrên,Zhouvàcs.(2022)báo
cáokếtquảthấphơnkếtquảcủachúngtôivới
53,68%E. coliđượcphânlậptừmẫuphếttrực
tràngcủachónuôinhà.Nhìnchung,vikhuẩn
E. colitồntạithườngtrựctrênđườngtiêuhóa;
cùngvớitỷlệphânlậpcao,chúngcókhảnăng
truyềnlâycácvậtchấtđềkhángngaycảkhithú
nuôikhôngcóbiểuhiệnlâmsàngvềbệnh.
3.2. Mức độ mẫn cảm kháng sinh của các gốc
vi khuẩn E. coli
Kết quả đánh giá mức độ mẫn cảm kháng
sinhcủa40gốcE. coliphânlậptừmẫuphân
chóđượctrìnhbàyởbảng1.
Bảng 1. Mức độ mẫn cảm kháng sinh của các gốc E. coli (n=40)
Kháng sinh
Nhạy cảm SDD* Trung gian Đề kháng
Số
gốc Tỷ lệ (%) Số
gốc Tỷ lệ (%) Số
gốc Tỷ lệ (%) Số
gốc Tỷ lệ (%)
Amoxicillin -
clavulanate 1 2,5 - - 6 15 33 82,5
Cefepime 19 47,5 2 5 - - 19 47,5
Imipenem 32 80 - - 6 15 2 5
Meropenem 32 80 - - 8 20 0 0
Amikacin 29 72,5 - - 10 25 1 2,5
Gentamicin 17 42,5 - - 2 5 21 52,5
Doxycycline 1 2,5 - - 15 37,5 24 60
Tetracycline 2 5 - - 0 0 38 95
Chloramphenicol 0 0 - - 0 0 40 100
Ciprofloxacin 5 12,5 - - 3 7,5 32 80
Norfloxacin 18 45 - - 19 47,5 3 7,5
Trimethoprim/
Sulfamethoxazole 11 27,5 - - 0 0 29 72,5
Ghi chú: *SDD: susceptible-dose dependent
Từkếtquảcủabảng1,cóthểnhậnthấysự
khácnhauvềmứcđộnhạycảmkhángsinhcủa
E. coli vớicáckhángsinhthửnghiệm.Trongđó,
cácgốcvikhuẩnkhôngnhạycảmhoàntoànvới
bất cứ kháng sinh nào trong số 12 kháng sinh
đượcthử nghiệm. CácgốcE. coliđã phân lập
nhạycảmcaonhấtvớicáckhángsinhimipenem,
meropenem,amikacinvớitỷlệcao(>70%).Các
kháng sinh còn lại như cefepime, gentamicin,
trimethoprim/sulfamethoxazolecótỷlệvikhuẩn
nhạycảmdưới50%.VikhuẩnE. coli nhạycảm
thấphơnvớiciprofloxacin(12,5%),tetracycline
(5%), doxycycline và amoxicillin-clavulanate
(2,5%).Trongđó, đáng lưuý không cógốc vi
khẩnE. colinàonhạycảmvớichloramphenicol.
Trên thực tế, những kháng sinh mà các vi
khuẩnE. coliphânlậpđượctrongnghiêncứu
nàyítnhạycảmlànhữngkhángsinhđãvàđang
đượcsửdụngrấtphổbiếntrongphòngtrịbệnh
trênchónóichung.

22
KHOA HỌC KỸ THUẬT THÚ Y TẬP XXXI SỐ 8 - 2024
Trongnhómβ-lactam,imipenemvàmeropenem
là các kháng sinh carbapenem phổ rộng được sử
dụng có điều kiện trong nhân y (Papp-Wallace
et al., 2011). Nhóm được xếp vào lựa chọn cuối
cùngtrongđiềutrịcáccanhiễmkhuẩnnặng,nghi
ngờnguyênnhândovikhuẩnđađềkháng,không
đáp ứng với các kháng sinh thế hệ mới nhóm
cephalosporin (Breilh et al., 2013). Nghiên cứu
củachúngtôi ghi nhận đây là những kháng sinh
màcácgốcE. coliphânlậpđượccómứcđộnhạy
cảmcaonhất,chiếmđến80%tổngsốgốcphânlập.
CácnghiêncứukhácchothấyE. coliphânlậptrên
chónhạycảmhoàntoànvớiimipenem(Namet al.,
2010;Marchettiet al.,2021).
Cácnghiêncứutrênnhânycũngcósựkhác
biệtlớnvềkếtquảnghiêncứutrênsovớikết
quảnghiêncứucủachúngtôi,vớichiềuhướng
giảmtỷlệnhạycảmcủavikhuẩnvớicáckháng
sinhthửnghiệm.Mộtkhảosátvềmứcđộmẫn
cảm kháng sinh trên 16 bệnh viện nhân y tại
ViệtNamchothấy6%E. colikhôngcònnhạy
cảmvớiimipenem(Vuet al.,2019).Điềuđáng
longạilàtỷlệsửdụngvàtiêuthụnhómkháng
sinhnàyđãtănglênđángkểtrongnhữngnăm
gầnđây.Tỷlệtiêuthụcarbapenemđãtăng45%
trongvòng10nămtừ2000đến2010tại71quốc
gia(QuynhvàDat,2021);tại30bệnhviệnvà
52cơsởytếcủaViệtNamnăm2018,chiphí
mua carbapenem đóng góp đáng kể vào ngân
sáchdùngchokhángsinh(10,12%)(Datet al.,
2020.)Việcgiatăngtỷlệsửdụngcóthểdẫnđến
tốcđộvikhuẩnđềkhángcáckhángsinhtuyến
cuốinàyngàymộtnhanhhơn.
Dưới 50% E. coli trong nghiên cứu của
chúng tôi còn nhạy cảm với cefepime, trong
khitỷlệnàylênđến99,5%ởnghiêncứukhác
(Namet al.,2010).Vềphíanhâny;85,1%các
bệnhnhântạiMỹnhiễmE. coligâynhiễmtrùng
đườngtiêuhóa cósảnsinh ESBL(Doiet al.,
2013);59%cácgốcvikhuẩnE. colisảnsinh
ESBLđượcghinhậntrên13bệnhviệntạiViệt
Nam(Vuet al.,2021).
Sựgiảmmứcđộnhạycảmcủavikhuẩnđối
với kháng sinh nhóm beta-lactam có thể liên
quantớinhiềucơchếkhácnhau.Trongđó,có
yếutốditruyềncủavikhuẩngramâm(E. coli)
đề kháng kháng sinh nhóm cephalosporin và
sự sản sinh các enzymes beta-lactamase giữa
ngườivàđộngvật(ĐặngThịThanhSơnet al.,
2016).Cácenzymenàycókhảnăngthủyphân
vàbấthoạtchứcnăngcủakhángsinh(Paterson,
2006).Thôngquanhữngcơchếtrên,vikhuẩn
cóthểpháttángenđềkhángkhángsinhquavật
nuôi,chủnuôiđếncộngđồng.Đánglưuý,chỉ
2,5%sốgốcE. colitrongnghiêncứunàycòn
nhạy cảm với amoxicillin-clavulanate. Đây là
khángsinhđượcsửdụngphổbiếntrongthúy,
mứcđộmẫncảmthấpchothấycáckhángsinh
cóphốihợpvớichấtứcchếbeta-lactamaseđã
bịđềkhángdần.
Ở nhóm aminoglycoside, E. coli cho mức
độnhạycảmvớiamikacincaohơngentamicin;
chiếmtỷlệ72,5%sovới47,5%.Cảhaikháng
sinhđềuchokếtquảnhạycảmthấphơnkếtquả
từcácnghiêncứukhác,vớiE. colinhạycảm
amikacin và gentamicin lần lượt là 99,2% và
82%(Namet al.,2010);E. coli nhạycảmhoàn
toànvớihaikhángsinh(Marchettiet al.,2021).
Các kháng sinh nhóm quinolon được thử
nghiệmtrongnghiêncứunàylànorfloxacinvà
ciprofloxacin,kếtquảvềtỷlệnhạycảmcủavi
khuẩncũngcósựkhácnhau.45%E. coliđãphân
lậpnhạycảmvớinorfloxacinvà12,5%cònnhạy
cảmvớiciprofloxacin.Kếtquảnàythấphơntỷ
lệ được công bố trong nghiên cứu củaAmadi
và cs. (2019) với 99,3% gốc vi khuẩn nhạy
cảmvớiciprofloxacin.Tỷlệnhạycảmcủacác
E. coli với kháng sinh phối hợp trimethoprim/
sulfamethoxazolelàthấphơn30%,tỷlệnàythấp
hơn rất nhiều so với các nghiên cứu trước đó,
lầnlượtlà95%(Stenskeet al.,2009)và94,8%
(Amadiet al.,2019).
CácgốcE. colicómứcđộnhạycảmrấtthấp
vớicáckhángsinhnhómtetracycline.Cụthể,tỷ
lệnhạycảmcủacácE. colivớidoxycyclinevà
tetracyclinechỉởmức2,5%và5%.Đâylàhai
khángsinhthườngđượcsửdụngtrongphòng
trịbệnhtrênchó.Tỷlệnhạycảmnàycũngthấp
hơnsovớicácnghiêncứukhácvớitỷlệnhạy
cảmcủaE. colilà73%-93%(Stenskeet al.,


























